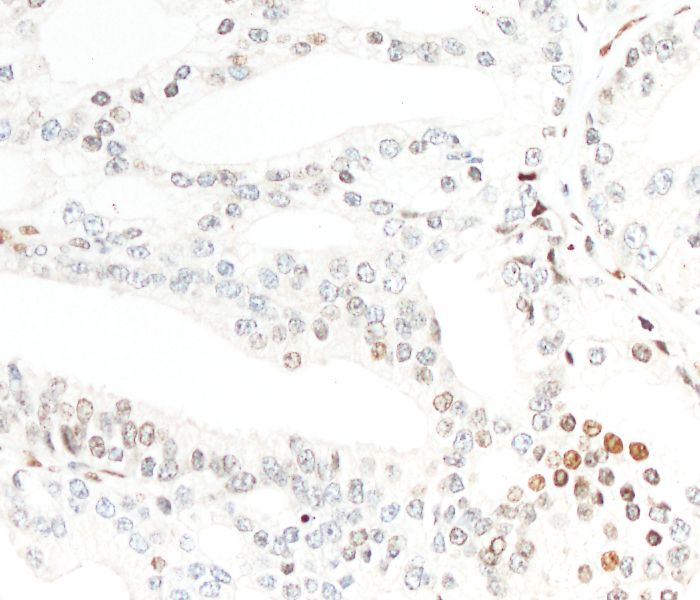
Lokal begrenztes, langsam wachsendes Prostatakarzinom

Prostatakrebs ist eine der häufigsten Krebserkrankungen in der westlichen Welt und betrifft überwiegend Männer ab dem Rentenalter. Es erkranken ca. 60.000 Männer an Prostatakrebs in Deutschland pro Jahr und ca. 13.000 versterben daran. Während der Tumor klinisch meist gut behandelbar ist, so hat doch ein erheblicher Anteil der Patienten eine schlechte Heilungschance. Bislang ist allerdings noch weitgehend unklar, warum der Großteil der Patienten mit einem Prostatakarzinom einen langsamen und damit gut kontrollierbaren Verlauf zeigt und ein kleinerer Anteil der Prostatakrebspatienten einen schnell fortschreitenden, meist tödlich endenden Krankheitsverlauf. Daher suchen Forscher heute nach den Ursachen für die unterschiedliche Entwicklung dieser Erkrankung, um zum einen den Verlauf bzw. das Fortschreiten des Prostatakrebses frühzeitig gut einschätzen und zum anderen die Grundlage für moderne Therapieansätze legen zu können.
Molekulare Merkmale gesucht
Ein Team um Prof. Dr. Sven Perner, Direktor der Pathologie des Universitätsklinikums Schleswig-Holstein und des Forschungszentrums Borstel, haben im Rahmen eines von der Wilhelm Sander-Stiftung geförderten Forschungsprojektes hierzu Gewebe von Prostatakrebspatienten in unterschiedlichem Stadium und mit unterschiedlichem Krankheitsverlauf untersucht. Ziel war es, molekulare Merkmale im Gewebe von Patienten, die einen guten klinischen Verlauf zeigten, mit den Merkmalen von Patienten zu vergleichen, die an dieser Erkrankung verstorben sind. Die Wissenschaftler haben dabei verschiedene Herangehensweisen gewählt.
Gezieltes Abschalten von Krebsstammzellen?
Zum einen wurden Gene und Proteine untersucht, die als sogenannte Stammzellen für die Selbsterneuerung von normalem Gewebe eine Rolle spielen. Dabei zeigte sich, dass das Stammzell-Gen EVI-1 bei der Selbsterneuerung von normalen Prostatazellen eine wichtige Rolle spielt, aber vor allem auch in den Krebsstammzellen des Prostatakarzinomgewebes von Patienten mit tödlichem Verlauf weiterhin „angeschaltet“ ist. Das Forscherteam geht davon aus, dass Krebsstammzellen eine wichtige Rolle beim Fortschreiten des Prostatakrebses und bei der Bildung von Metastasen spielen. „Wir sind davon überzeugt, dass das gezielte Abschalten dieser Krebsstammzellen einen guten Ansatz für eine verbesserte Therapie darstellt“, sagt Sven Perner.
Mediatorkomplex spielt zentrale Rolle
In zwei weiteren Veröffentlichungen hat das Forscherteam einen erst vor einigen Jahren entdeckten Eiweißkomplex im Rahmen von Krebserkrankungen untersucht. Dieses Molekül, Mediatorkomplex genannt, – für dessen Entdeckung 2006 der Nobelpreis für Physiologie oder Medizin an Andrew Z. Fire und Craig C. Mello vergeben wurde – ist in normalen Zellen eine wichtige Schaltstelle bei der Bildung von Eiweißmolekülen aus dem Erbgut einer Zelle. Perner und seine Mitarbeiter konnten unter Verwendung von großen molekularen Datenbanken zeigen, dass dieser Mediatorkomplex auch bei verschiedenen Krebserkrankungen eine zentrale Rolle spielt. So gelang es den Forschern, nachzuweisen, dass unterschiedliche Anteile dieses Eiweißkomplexes bei verschiedenen Krebsarten charakteristische Veränderungen aufweisen. Durch weiterführende Experimente fanden die Wissenschaftler exemplarisch am Prostatakrebs heraus, dass bestimmte Schrittmacher der Genaktivität – sogenannte Proteinkinasen – bei der Entstehung des Tumors mit oft tödlichem Verlauf eine starke Aktivität aufweisen. Diese Aktivität konnte durch selbst hergestellte spezifische Blocker in Zellkultur-Experimenten aufgehoben werden. Damit hoffen die Forscher, einen weiteren wichtigen Schlüssel zum Entstehen und Fortschreiten des Prostatakrebses gefunden und eine wesentliche Grundlage für die Entwicklung zielgerichteter Medikamente gegen diese Krankheit geschaffen zu haben. (idw, red)
1. Syring, I., Klümper, N., Offermann, A., et al.: Comprehensive analysis of the transcriptional profile of the Mediator complex across human cancer types. Oncotarget. 2016 Apr 26; 7 (17): 23043-55. DOI: 10.18632/oncotarget.8469.
2. Brägelmann, J., Klümper, N., Offermann, A., et al.: Pan-cancer analysis of the Mediator complex transcriptome identifies CDK19 and CDK8 as therapeutic targets in advanced prostate cancer. Clin Cancer Res. 2017 Apr 1; 23 (7): 1829-1840. DOI: 10.1158/1078-0432.CCR-16-0094. Epub 2016 Sep 27.
3. Queisser, A., Hagedorn, S., Wang, H., et al.: Ecotropic viral integration site 1, a novel oncogene in prostate cancer. Oncogene. 2017 Mar; 36 (11): 1573-1584. DOI: 10.1038/onc.2016.325. Epub 2016 Sep 12.
4. Offermann, A., Vlasic, I., Syring, I., et al.: MED15 overexpression in prostate cancer arises during androgen deprivation therapy via PI3K/mTOR signaling. Oncotarget. 2017 Jan 31;8(5):7964-7976. DOI: 10.18632/oncotarget.13860.
Artikel teilen